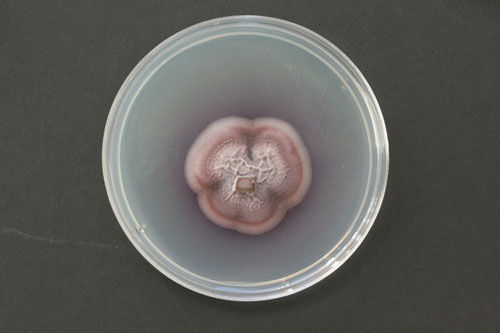

粉红粘帚霉

发现此真菌的美国蒙大纳州大学保兹曼分校的加里·斯托贝尔说:“地球上没有其它已知生物能做到这个,我想此气体混合物足可以驱动发动机。”加里在粉红粘帚霉中确定了此柴油气体。此真菌生活在植物细胞之间。他确定此真菌产生的此气体能杀死其它真菌。
对此气体成分分析表明它富含有柴油中所发现的碳氢化合物,如辛烷。此外,他确定其里面还有低分子量的乙醇和酯,二者混合可以较普通柴油燃烧更清洁更有效。这种高含量的纯碳氢化合物意味着它比甘蔗生产的生物乙醇燃烧更好,后者含有氧原子,因此较碳氢化合物的能量要少。
纤维素红利
其它红利是此真菌可以生长在纤维素上,而纤维素含有大量的碳氢化合物,但特别难分解。加里说:“纤维素是地球上最丰富的有机化合物,但大多数给浪费掉了。”通过纤维素上的这种真菌发酵,可以产生大量现成的柴油气体。但还需要做更多的实验来证实此想法的可行性。加里说:“我们将做更大规模的测试,进行发酵后让此真菌产生足够多的柴油气体来驱动一台小发动机。如果我们能做到这一点,我们就能对它进行交易。”
双倍价值
加里表示此真菌有双倍价值,因为它含有独特的基因,能生产出将纤维素分解成柴油气体的酶。从理论上说,当把它嫁接到其它生物体中时,这些真菌将更加活跃,将更加有效地生产柴油。另一项特别的可能性是燃料石油不仅仅是由有机物在高温高压产生,还可能是微生物的杰作。加里说:“人们一直认为所有石油是由这些地球物理学过程产生的,全我们认为还可能是由微生物过程生产的。因此我们可以通过全部绿色的过程来生产我们的原油。”此发现发表在最新出版的《微生物学》杂志上。(尼特) (本文来源:网易探索 )



